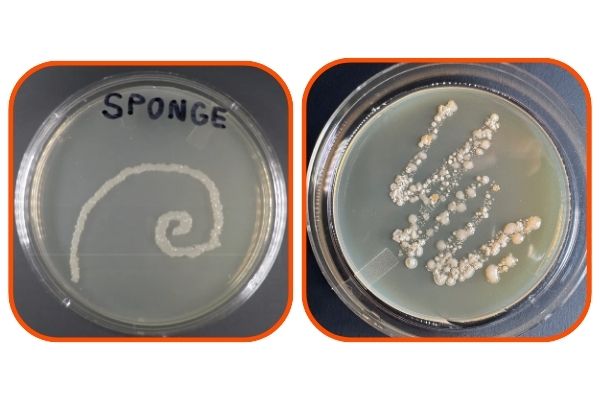

Microwaving might seem like a quick fix, but studies show it's largely ineffective long-term.
A 2017 study by Cardinale et al. in Scientific Reports found that while microwaving reduces some bacteria, the strongest, most pathogenic strains survive and regrow quickly. University of Arizona research (2022) revealed microwaving only eliminates 60% of bacteria, leaving deep-seated germs untouched due to the sponge's structure.
Even a 2007 USDA study, which claimed 99.99999% kill rate, has been contradicted by newer findings showing regrowth.
Why? The cavernous pores trap food residue and bacteria deep inside, preventing full penetration. As per a 2022 Duke University study in Nature Chemical Biology, this structure fosters diverse microbial interactions, making sanitization temporary at best. Instead of risking it, replace regularly. SpongeMail's fade-to-replace designs remind you when it's time, leveraging visual cues for better habits.